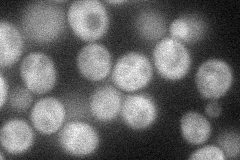
YLR006C
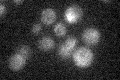
YLR006C

View description
Cytoplasmic response regulator, part of a two-component signal transducer that mediates osmosensing via a phosphorelay mechanism; dephosphorylated form is degraded by the ubiquitin-proteasome system; potential Cdc28p substrate
Localization:
Intensity:
Fold change:
Significance:
-
C’ GFP library in SD

below threshold16.03 -
N' NOP1pr-GFP in SD
cytosol39.0351 -
N' TEF2pr-mCherry in SD

cytosol35.3522 -
N' NATIVEpr-GFP in SD

cytosol27.3563 -
N' TEF2pr-VC and Cyto-VN in SD

#N/A0 -
C’ GFP library in SD+DTT

cytosol17.651.1No -
C’ GFP library in SD+H2O2

cytosol18.41.14No -
C’ GFP library in Starvation Media
cytosol16.061No -
C’ GFP library on the background of Pup2-DaMP

below threshold -
C’ GFP library on the background of CCT mutant

below threshold19.79771.23441No
